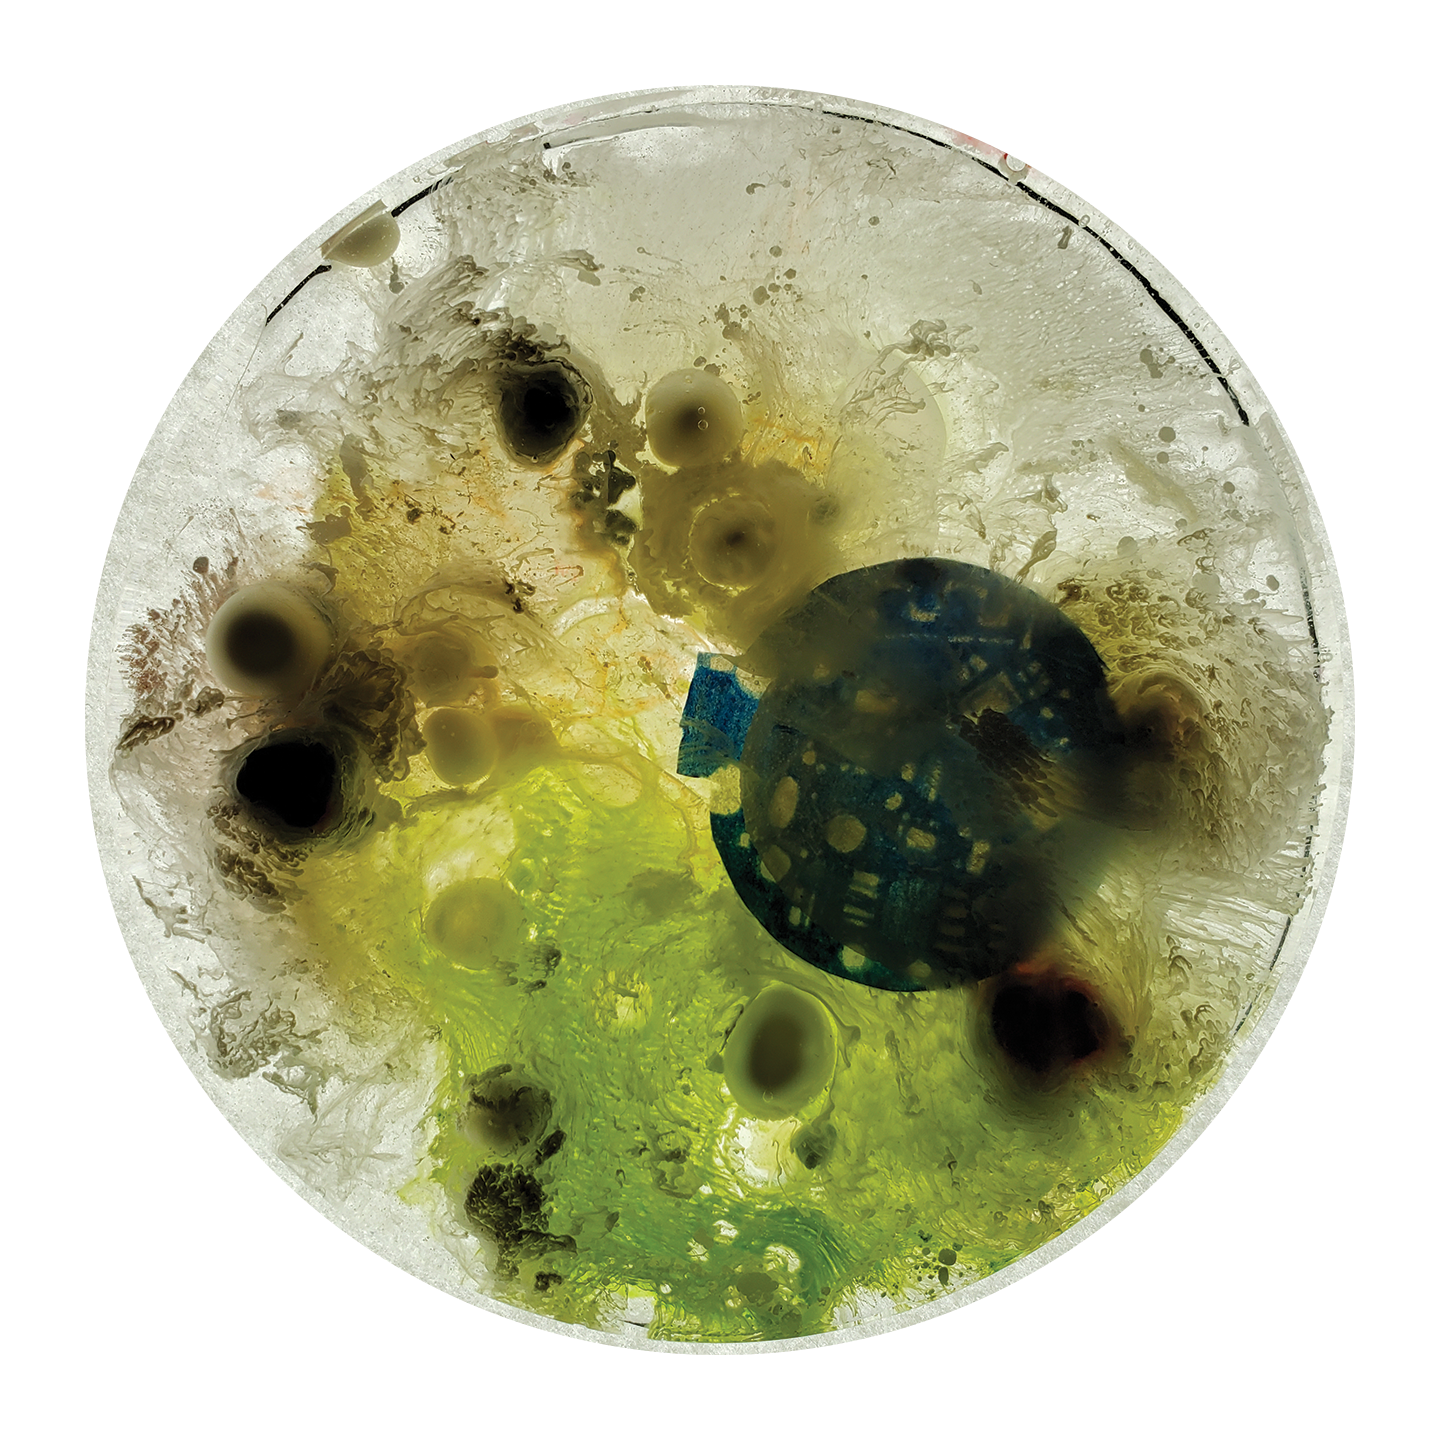

“Diagram of the Sensory Today (Seen)”, 2021
Acrylic, colored pencil, and watercolor on paper.
8.5”x11”
“Diagram of the Sensory Today (Heard)”, 2021
Acrylic, colored pencil, and watercolor on paper.
8.5”x11”
"One Body" (1/2) (2020) Acrylic and watercolor on paper. 12"x9"
"One Body" (2/2) (2020) Acrylic and watercolor on paper. 12"x9"
"Wired Bodies 4" (2020) Acrylic, watercolor, ink, and colored pencil on paper. 12"x9"
"Wired Bodies 1" (2020) Acrylic, watercolor, ink, and colored pencil on paper. 8"x10"
"Wired Bodies 2" (2020) Acrylic, watercolor, ink, and colored pencil on paper. 14"x12"
"Wired Bodies 3" (2020) Acrylic, watercolor, ink, and colored pencil on paper. 14"x12"
"New Normal" (detail) 2020 Acrylic, colored pencil, string, and found electronic parts on duralar, canvas paper, and watercolor board with t-pins.
"New Normal" (installation) 2020 Acrylic, colored pencil, string, and found electronic parts on duralar, canvas paper, and watercolor board with t-pins.

"KM 03-21 TSA/DIDP 01", 2021 Acrylic, circuit board components, and ink in petri dish. 3.75” dia.

"KM 03-21 TSA/DIDP 02", 2021 Acrylic, circuit board components, and ink in petri dish. 3.75” dia.

"KM 03-21 TSA/DIDP 03", 2021 Acrylic, circuit board components, and ink in petri dish. 3.75” dia.

"KM 03-21 TSA/DIDP 04", 2021 Acrylic, circuit board components, and ink in petri dish. 3.75” dia.

"KM 03-21 TSA/DIDP 05", 2021 Acrylic, circuit board components, and ink in petri dish. 3.75” dia.

"KM 03-21 TSA/DIDP 06", 2021 Acrylic, circuit board components, and ink in petri dish. 3.75” dia.

"KM 03-21 TSA/DIDP 07", 2021 Acrylic, circuit board components, and ink in petri dish. 3.75” dia.

"KM 03-21 TSA/DIDP 08", 2021 Acrylic, circuit board components, and ink in petri dish. 3.75” dia.

"KM 03-21 TSA/DIDP 09", 2021 Acrylic, circuit board components, and ink in petri dish. 3.75” dia.

"KM 03-21 TSA/DIDP 10", 2021 Acrylic, circuit board components, and ink in petri dish. 3.75” dia.
“Figure 3 X-ray”, 2021
Acrylic, colored pencil, graphite, ink, and watercolor on paper.
16”x12”
“Interior Perceived Post-Exposure”, 2021
Acrylic, colored pencil, graphite, ink, and watercolor on paper.
12”x16”
“Manus X-ray Digitization”, 2021
Colored pencil, graphite, ink and watercolor on paper.
11”x8.5”
“Microscopic Shots of the Human Int. Post-Exposure 1”, 2021
Colored pencil, gel medium, glass beads, ink, and watercolor on paper.
5.5” x 5.5”
“Microscopic Shots of the Human Int. Post-Exposure 2”, 2021
Colored pencil, gel medium, glass beads, ink, and watercolor on paper.
5.5” x 5.5”